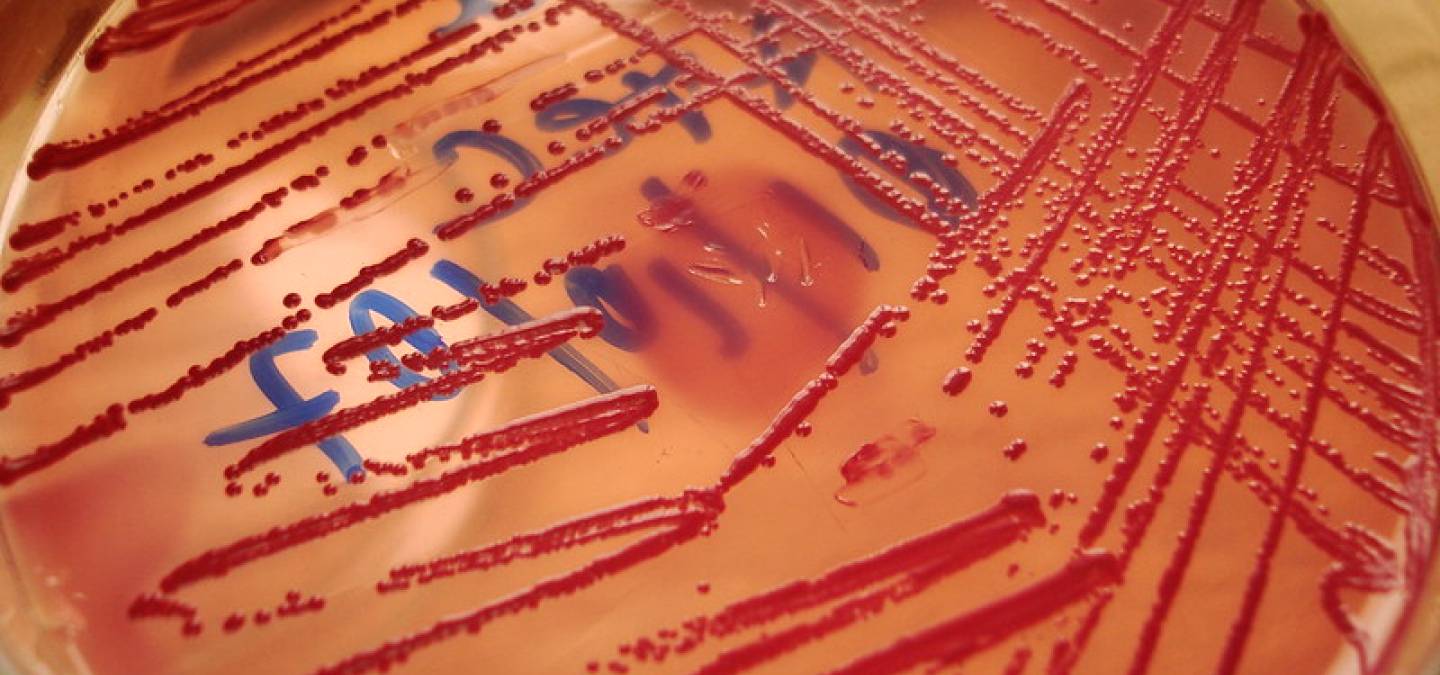

Cette brève explique ce que l'on désigne par « altruisme » au sein des populations bactériennes.
Introduction
L’altruisme est un comportement qui permet d’obtenir un bénéfice pour une population, moyennant un éventuel désavantage pour l’individu altruiste. On connaît de nombreux exemples d’altruisme chez les animaux. Citons l’exemple des marmottes chez lesquelles un individu monte la garde et prévient le groupe de l’arrivée d’un danger en criant, au risque d’être plus facilement repéré et d’être la première victime de ce danger (par exemple, arrivée d’un prédateur).
Mais dans un travail publié dans la revue Nature, pour la première fois des chercheurs ont montré l’existence d’un comportement altruiste chez les bactéries. Ce résultat, intéressant sur le plan fondamental, pourrait également avoir des retombées pratiques puisque le comportement observé consiste en l’acquisition de la résistance d’une population bactérienne à un antibiotique. On voit immédiatement en quoi la découverte d’un tel mécanisme peut intéresser le monde médical.
Les faits
Dans la vision classique que nous avons de l’acquisition de la résistance à un antibiotique d’une souche bactérienne, la présence d’un antibiotique dans une culture bactérienne entraîne la sélection des quelques bactéries résistantes à cet antibiotique. A la suite de quoi, ces bactéries résistantes se multiplient pour donner une population résistante.
Mais les travaux de l’équipe de James Collins (voir la référence) ont fait apparaître un fait nouveau. Dans cette étude, une population de bactéries Escherichia coli a été soumise à des concentrations croissantes d’un antibiotique (la norfloxacine, famille des quinolones, voir l’article « La pénicilline, découverte d’un antibiotique »). Les résultats ont montré que les bactéries isolées étaient généralement beaucoup plus sensibles à cet antibiotique que l’ensemble de la population bactérienne. En d’autres termes, le fait d’être en groupe apporte une plus grande probabilité de survie à cet antibiotique.
L’explication
Les auteurs ont bien entendu cherché à découvrir le mécanisme sous-jacent à cette plus grande résistance de la population comparée à celle de la somme de ses parties. Ils ont trouvé que les quelques bactéries les plus résistantes aidaient les autres bactéries de la colonie, moins résistantes, à résister à l’antibiotique par le biais de la production d’une molécule appelée indole. Cette molécule active certains gènes des bactéries cibles, gènes codant pour des molécules impliquées dans l’efflux actif des drogues ainsi que dans la résistance au stress oxydatif.
Pourquoi peut-on dès lors parler d’altruisme ? D’une part car c’est le contraire du comportement égoïste qui consisterait à ne pas aider les autres bactéries et à profiter de leur disparition pour proliférer plus facilement (diminution de la compétition). D’autre part car cette aide a un coût pour la bactérie résistante : si on met en compétition des bactéries résistantes qui ne produisent pas d’indole avec des bactéries résistantes qui produisent de l’indole, ces dernières perdent la compétition. En effet, produire de l’indole a un coût énergétique qui ne donne pas un avantage aux individus qui le produise. On a donc bien un comportement altruiste : bénéfique au niveau de la population mais au prix d’un désavantage pour les individus altruistes. Il est bien évident qu’on ne parle pas ici de choix raisonné de la part des organismes impliqués (une bactérie n’a pas de système nerveux…) mais de la description d’un comportement qui correspond à la définition du mot altruiste.
Perspectives
En laissant volontairement de côté les développements théoriques qu’un tel résultat appelle, on peut envisager que cette découverte amène à modifier les modalités pratiques de l’antibiothérapie. En effet, l’émergence de souches résistantes, et parfois même multirésistantes, de bactéries devient un enjeu de santé publique. Ce travail porte en lui l’espoir de modifier les modalités des traitements antibiotiques de façon à augmenter leur efficacité, donc limiter les quantités nécessaires et peut-être l’émergence de souches résistantes. Comme tout résultat novateur, plus qu’une réponse à une question, il ouvre la porte à de nombreux travaux.
Référence
Henry H. Lee, Michael N. Molla, Charles R. Cantor et James J. Collins. Bacterial charity work leads to population-wide resistance. Nature (2010) 467:82-85